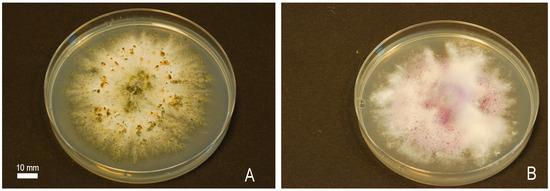

Abstract
Tobacco mosaic virus (TMV) is one of the most persistent and infectious plant viruses. The substantial economic losses caused by TMV in the production of tobacco and vegetables (especially in the Solanaceae family) are prompting the introduction of innovative solutions that effectively inhibit infection by this pathogen. Biological control agents based on bacteria of the genera Pseudomonas, Bacillus, Pantoea and actinomycetes are becoming increasingly popular in the fight against TMV. Some fungi, including Fusarium spp., Trichoderma spp., Alternaria spp. and Sepedonium spp., as well as wood-rotting fungi, also exhibit high anti-TMV activity. This article presents a comprehensive review of recent scientific advances in the bioprotection of selected solanaceous crops against TMV. It provides information on the structure of the virus, its host range, pathogenicity and the severity of losses caused in pepper, tomato and tobacco production. The review characterises environmentally safe techniques involving biological control agents naturally occurring in the environment and the bioactive compounds extracted from them. It also identifies their effects on crops at the morphological, physiological and molecular levels. In addition, the manuscript outlines prospects for the future applications of beneficial micro-organisms and active compounds derived from them in the protection against TMV.
1. Introduction
1.1. Tobacco Mosaic Virus
Tobacco mosaic virus (TMV) was one of the first viruses to be identified and is also one of the most infectious plant pathogens [1]. It belongs to a large group of viruses classified in the genus Tobamovirus in the family Virgaviridae. Its genome is composed of a single-stranded RNA (ssRNA) that is encapsidated in a protein capsid [2]. The protein capsid is composed of 2130 small protein subunits arranged as a helix [3]. Despite a comprehensive understanding of the virus’s structure and transmission mechanisms, TMV continues to cause significant economic losses worldwide that exceed $100 million annually [4]. Yin et al. [5] reported that TMV infects more than 400 species belonging to 36 botanical families. It occurs on numerous weeds [6] and ornamental species [7]. The most important crops affected by TMV include pepper, tomato, aubergine and tobacco [1]. The symptoms of virus infection can vary considerably between hosts, and may take the form of mosaic discolouration in the form of light and dark green spots on leaves, stunting, leaf curling and the yellowing of plant tissue. TMV strains infecting pepper have been observed to cause non-uniform fruit colour, distortion and delayed ripening [8,9]. Infected plants display stunted growth, dwarfism and often die, which leads to reduced yields. According to Pernezny et al. [10], yield losses due to TMV in pepper cultivation can reach 30%. In contrast, Chitra et al. [11] reported a yield loss of almost 90% as a result of early TMV infection in bell peppers. In tomato, TMV infection causes necrotic pitting, bronzing or severe mottling, and occasionally results in an irregular shape of infected fruits. The percentage range of diseased fruits at different stages of infection was 19–33% [12]. In field-grown, machine-harvested tomatoes in Italy, a 10% increase in the infection rate was associated with a 4.4% decrease in the average yield [13]. Additionally, TMV has been demonstrated to infect potato plants through artificial inoculation, resulting in the development of symptoms such as dwarfing and leaf dropping, bright mosaic patterns, severe stunting and stem necrosis [14,15,16]. However, the observed yield losses were not significant. On tobacco, TMV causes discolouration on young leaves, which subsequently exhibit a mottled or mosaic pattern of light and dark green areas (Figure 1A). This is followed by the development of dwarfed leaves (Figure 1B). Small necrotic spots may appear on cultivars exhibiting a hypersensitivity reaction (Figure 1C). Severe symptoms of infection with this virus were observed on tobacco plants in the United States in the late 20th and early 21st centuries [17]. In 2000, the estimated losses in tobacco yield in North Carolina (USA) due to TMV infection were in excess of 10 million dollars [18]. Currently, yield losses for tobacco due to TMV in this country are estimated at a few or several percent due to the entry of cultivation-resistant varieties. Conversely, in European countries with a moderate climate zone, increased losses due to TMV in tobacco are attributed to the combined effects of global warming and the lack of resistant cultivars [19].

Figure 1.
Disease symptoms of tobacco mosaic virus (TMV) inoculation on different tobacco cultivars: (A) Nicotiana tabacum cv. Wiślica (mosaic pattern of light and dark green areas observed in field conditions), (B) N. tabacum cv. Ambalema showing characteristic TMV infection puckering, wrinkling and waving of leaf blades (observed in a bioassay under greenhouse conditions), (C) hypersensitivity reaction (HR) to TMV infection in the form of small necrotic spots on the leaves of the cultivar KY 10. Source: author’s documentation.
1.2. Bioprotection in the Control of Tobacco Mosaic Virus
The TMV virus is highly stable. Unlike most other viruses, it can persist for many years on the surface of seeds, in soil and in the dead tissue of diseased plants. Virus particles can also survive on tools and work clothes, constituting a source of infection [20]. In addition to its high persistence in the environment, the virus also presents an obstacle due to the ease with which it spreads. It is easily transmitted by mechanical inoculation, grafting and contact between plants [21].
Prevention of TMV in crops is extremely challenging, due to the lack of effective chemicals. Furthermore, pesticides designed to inhibit a virus may have adverse effects on the host plant, humans and the environment. A number of studies have indicated a correlation between exposure to pesticides and an increased incidence of cancer and neurodegenerative diseases [22]. Consequently, there has been a significant increase in demand for bioprotection products which, according to the International Biocontrol Manufacturers’ Association [23], are nature-based or nature-identical solutions to managing crop pests and diseases. There are many reasons for using bioprotection strategies. Firstly, in contrast to pesticides, they do not give rise to residues in products, especially fresh ones. Furthermore, due to their high specificity, they are less harmful to beneficial organisms [24]. Another noteworthy advantage over pesticides is their lower phytotoxicity to plants and its lower negative impact on human health and the environment [25]. In light of the increasing problems with agrophage resistance to chemical pesticides, biogenic pesticides can be a very good alternative for the protection of many crops under both conventional and organic farming conditions [26]. Furthermore, an additional argument for further research on biological agents, nature-based substances and their application in agricultural practice is the Directive 2009/128/EC on the sustainable use of pesticides and integrated pest management, introduced in the European Union in 2014. Moreover, the EU Regulation 2021/2115, introduced in 2021 as part of the ‘From Field to Table’ strategy, which aims to reduce of the use of chemical plant protection products by 50% by 2030, has resulted in increased interest in bioprotectants.
This paper addresses strategies for the protection of solanaceous crops against TMV in accordance with the most recent definition of bioprotection. These measures include the use of biological control agents (BCA), including viruses, pathogenic or competitive micro-organisms (e.g., bacteria, fungi and actinomycetes) and beneficial macro-organisms (i.e., predatory mites and insects, and parasitic insects) [27]. They may also include compounds of plant or animal origin, including extracts, active molecules, proteins, alkaloids, phenolic compounds, oils and chitosan [24,27]. Furthermore, plant growth regulators are included in this category.
This review presents the characteristics of the tobacco mosaic virus and the range of its hosts. In addition, the bioprotection potential against TMV for the economically most important solanaceous crops is discussed. Particular attention is given to the efficacy of microbial bioprotection products, including bacteria, fungi, actinomycetes and their metabolites or cell fragments, in reducing TMV. Furthermore, the opportunities for the development of research on non-chemical methods and the implementation of their effects on agricultural practice are also discussed.
2. The Use of Bacteria in the Bioprotection of Solanaceaous Crops against Tobacco Mosaic Virus
Micro-organisms, including bacteria, are widespread in the world. They are found in all climatic zones, occupying various ecological niches. They have the capacity to multiply and spread rapidly, and to produce numerous compounds that affect other organisms, such as plants, animals, fungi or viruses. Some soil bacteria present in the root zone, and non-pathogenic endophytic bacteria referred to as PGPR (Plant Growth Promoting Rhizobacteria), are believed to assist plants in obtaining nutrients from the soil [28], produce hormone-like substances, thereby stimulating plant growth and yield [29], and reduce oxidative stress [30]. A further beneficial effect of PGPR is the induction of natural defence responses against pathogens in plants, including induced systemic resistance (ISR) [31]. A number of studies on tomato demonstrated that PGPR could trigger ISR to viruses, including TMV. The triggers of the ISR response are bacterial cells, surface components of bacterial cell walls and siderophores [32]. The signalling molecule for non-specific plant resistance is jasmonic acid (JA) and ethylene [31].
2.1. Rhizospheric Bacteria
2.1.1. Pseudomonas spp.
The rhizosphere bacteria of the genera Pseudomonas, Bacillus and Streptomyces are the primary agents responsible for inducing the ISR mechanism and protecting plants against pathogenic viruses, including TMV [33] (Table 1). As early as the turn of the 20th century, De Meyer et al. [34] showed that the PGPR Pseudomonas aeruginosa (Migula), which had previously been reported to induce resistance to soybean stunt virus (SSV) in soybeans, could also induce resistance to TMV in tobacco. The application of P. aeruginosa isolate 7NSK2 on the roots of tobacco seedlings of cv. Samsun NN that had previously been inoculated with TMV led to a significant reduction in lesion diameter (2.4 mm) in comparison to that recorded on the control (3.9 mm). However, it did not provide complete protection against TMV infection. Subsequent detailed examination of plant-resistant gene expression revealed that the induced resistance elicited by P. aeruginosa 7NSK2 was not accompanied by an increase in the expression of PR1a, leading to an inadequate plant response. The effect of the rhizosphere PGPR bacteria P. putida (Migula) on the induction of systemic resistance to TMV in tobacco was also studied by Gupta et al. [35]. The authors demonstrated that the foliar spray of the P. putida isolate P1f significantly induced the hypersensitivity response in tobacco leaves of the Xanthi cultivar, in comparison to the antiviral CAP-34 protein extracted from Clerodendrum aculeatum (L.) Schltdl. On the fifth day following TMV infection, the resistance response was 90% in the P1f-treated set and 79% in the CAP-34-treated set. The induced resistance in tobacco was associated with an increase in hydrogen peroxide content and peroxidase production in leaves. This effect was observed to persist only a few days after spraying, indicating a short-lived effect of the bacteria. Therefore, for effective virus control, the treatment had to be repeated to prolong the antiviral effect. Further investigation is also required to confirm the anti-TMV activity of the CAP-34 protein in field experiments.

Table 1.
Bacterial, actinomycetous and fungal bioprotectants with anti-TMV activity used in solanaceous crops and other species.
In a subsequent greenhouse experiment conducted on tomatoes, a significant decrease in disease incidence was recorded in plants treated with CAP-34 and isolate P1f, as compared to a control (receiving distilled water). The disease incidence of tomato plants treated with CAP-34 and P1f was 30 and 60%, respectively, 28 days post-inoculation. The slow increase in the number of symptomatic plants or the delayed development of symptoms in some plants within the treated sets may be attributed to an impairment in the movement of the virus or in the virus-replication process [35].
2.1.2. Bacillus spp.
The group of rhizosphere micro-organisms that limit the development of plant viral diseases also includes bacteria of the genus Bacillus [37]. This is a group of Gram-positive bacteria with a cylindrical shape, which are widely distributed throughout the world due to their ability to form spores that allow the bacteria to survive in unfavourable conditions for growth. They can be isolated from soil, fresh and saline waters and from stored, perishable food. Bacillus spp. Show great potential for plant bioprotection, primarily due to their capacity to produce antibiotics and enzymes such as proteases and amylases [60]. Analysis of the Bacillus spp. Genome revealed the presence of large clusters of genes responsible for the production of surfactins and fengycin lipopeptides, which are essential for the activation of induced systemic resistance [61].
It has been shown that some isolates of the Bacillus exhibit antiviral activity. Zhou et al. [36] examined the antiviral activity of 956 isolates belonging to the genus Bacillus, sourced from more than 300 plant samples, including maize seeds, tea leaves, herbs and wild plants native to China. The authors selected four isolates exhibiting the highest levels of antiviral activity in bioassays performed on Chenopodium amaranticolor (H.J. Coste and A. Reyn.) H.J. Coste and A. Reyn. Finally, the authors used isolate ZH14, isolated from Anxi Oolong tea leaves, for further greenhouse studies. They showed that the efficacy of the bacterial suspension as an elicitor varied depending on its preparation. The cell-free filtrate of ZH14, when added to the inoculation mixture, resulted in a slowing of TMV replication and a reduction in symptoms, with an inhibition percentage of 94.2%. In contrast, the broken cell suspension of ZH14 showed the weakest percentage inhibition at 3%. The duration of the induced resistance was relatively brief, lasting only a few days. Accordingly, in order to guarantee the most efficacious control of the virus, the authors suggested repetition of the treatment. Further detailed morphological and physiological analysis, involving a number of tests including the production of oxidase and catalase, indole, nitrate reduction, nucleic acid degradation, salt tolerance, temperature, as well as a comparative analysis of 16S rDNA sequences, permitted the classification of the studied isolate ZH14 as belonging to the B. cereus (Frankland and Frankland) species [36]. The authors stated that the B. cereus isolate ZH14, and its culture filtrate in particular, will find a wide range of application in the biological protection of numerous plant species, including N. tabacum (L).
In a subsequent study by Rajaofera et al. [37], it was demonstrated that the soil treatment with B. atrophaeus strain HAB-5 isolated from the cotton rhizosphere improved the growth of N. tabacum cv. Samsun H subjected to TMV inoculation. The positive effect of the bacteria was evidenced by a significant increase in fresh shoot weight, dry shoot weight, fresh root weight and dry root weight compared with the non-inoculated control plant. Furthermore, the presence of mosaic symptoms on leaves was significantly reduced, and total chlorophyll content was increased compared to the non-inoculated control plants.
Another set of experiments involving the application of a crude extract from strain B. artophaeus HAB-5 as a spray 12 h prior to tobacco TMV inoculation showed that plants exhibited significantly weaker disease symptoms and a threefold lower TMV virus accumulation in tissues compared to in unprotected plants. Furthermore, it was demonstrated that strain HAB-5 could inhibit the accumulation of ROS (reactive oxygen species) and cell death in leaves during TMV infection, and also participate in the induction of regulatory genes (NPR1) and resistance genes (PR-1a, PR-1b). The induction of systemic plant resistance was observed when Bacillus and Brevibacterium were used in the biocontrol of Capsicum annuum L. var. TM 999 against TMV [38]. The application of a pre-sowing of a hot-pepper seed treatment, in addition to soil inoculation with three of the eight selected PGPR isolates (I-35, I-16, I-6), delayed the rate of mosaic development by 5 to 10 days, in comparison to the unprotected control. Furthermore, the severity of disease symptoms was much lower, ranging from 2.7 to 3.3 in bacterized plants, compared to 8.0 in the control. In addition, plants treated with isolates I-1, I-16, I-35 and II-5 (109 CFU mL−1) exhibited, respectively, a five-, four-, three- and twofold increase in the activity of peroxidase (PO), an enzyme involved in plant defence response, when exposed to the pathogen. Peroxidase is known to function in the oxidation of phenols to quinones, thereby accelerating the polymerisation of phenolic compounds into lignin-like substances. The deposition of these substances in the cell walls then results in the interference with both virus movement and the expression of symptoms. At the same time, root colonisation by isolate I-35, identified based on the nucleotide sequencing of the 16S r-RNA as B. cereus, resulted in the best plant growth [38].
2.2. Combined Bacterial Suspensions
An innovative approach to the reduction of viral infections using bacterial cultures is the preparation and the use of two- or three-component biopreparations containing micro-organisms belonging to different species. A review of the literature indicates that the combined use of several bacteria in a single protective treatment can increase the efficacy of limiting viral infections. Of particular interest is a study on the reduction of TMV incidence and disease symptom severity on tomato seedlings [39], where plant inoculation was preceded by a foliar treatment using single-species suspensions containing P. fluorescens (Flügge) Migula, P. putida (Trevisan) or B. subtilis, as well as two- or three-species suspensions of the aforementioned bacteria. A foliar treatment using single- and dual-species suspensions at a concentration of 108 CFU mL−1 resulted in a significant reduction in the severity of disease symptoms compared to the positive control (TMV-inoculated plants) at both 3 and 6 weeks post-infection. This treatment also led to a significantly higher chlorophyll index and plant height. The combination of two bacterial species demonstrated superior efficacy compared to their individual use, while the addition of a third species resulted in a reduction in the severity of the mosaic and an improvement in chlorophyll content, plant height and aboveground weight and underground weight. The authors concluded that the bacteria used in the experiment demonstrated a strong synergistic effect, and that their high efficacy in reducing TMV symptoms could be attributed to this synergy.
Another example of the positive effect of combined bacterial suspensions using P. fluorescens, P. putida and B. subtilis (Ehrenberg) Cohn is the stimulation of systemic resistance in C. annuum. Aeini et al. [40] demonstrated that a pre-sowing, soilless medium application of a three-species bacterial suspension, applied prior to plant inoculation with the virus (TMV-PU1), did not fully protect the plants from infection. The recorded disease severity was 32.0, which was significantly lower than that of the positive control (78.66). The stimulation of roots by the bacteria induced defence responses in the aboveground part of plants through the induction of systemic resistance (ISR) 28 days after virus infection. ISR was expressed by a statistically significant increase in activity of antioxidant enzymes, including superoxide dismutases (SOD), catalase (CAT), peroxidase (POD) and ascorbate peroxidase (APX), which converted reactive oxygen species into non-toxic compounds. An increase in antioxidant enzyme activity induced resistance against the virus and lowered the ELISA extinction value. Furthermore, it was demonstrated that the colonisation of pepper roots by the three PGPR species resulted in a significant increase in chlorophyll content, plant height, root fresh weight and aboveground dry weight, in addition to providing some protection against TMV (low disease severity) compared to controls treated with TMV alone, as well as non-inoculated plants [40].
2.3. Phyllospheric Bacteria
In addition to rhizospheric bacteria, microbial communities inhabiting the phyllosphere are increasingly used in biological crop protection. The communities inhabiting the aboveground part of plants are a very complex and dynamic community. They consist mainly of endophytic and epiphytic bacteria, but also of yeasts, filamentous fungi, less algae and seaweed. These communities play an important role in protecting plants against virus pathogens [62].
On the leaf surface, bacteria of the genera Pseudomonas, Enterobacter, Pantoea and Bacillus are most commonly identified. Of particular note is the species B. velezensis, whose strain SYL-3, isolated from tobacco leaves, showed high efficacy against Alternaria alternata (Fr.) Keissl., but also against TMV in a field experiment [41]. A study conducted on leaves of N. glutinosa (L) showed that SYL-3 treatment significantly suppressed mosaic leaf symptoms from 8.89 (control treatment) to 2.83. The inhibitory rate of SYL-3 against TMV was 68.11%. The protective effect of strain SYL-3 was found to be multilevel. It was noted that there was an increase in the abundance of Pseudomonas, Sphingomonas and Cladosporium. The abundance of the aforementioned micro-organisms, particularly Pseudomonas in the phyllosphere of the tobacco plants, was negatively correlated with the disease index caused by TMV. Furthermore, it was observed that an increased proportion of Pseudomonas and Sphingomonas was positively correlated with the presence of the beneficial micro-organisms Stenotrophomonas and Methylobacterium.
2.4. Biogenic Nanoparticles Coated with Bacteria
In recent years, a very promising approach to the use of micro-organisms in biological crop protection seems to be a technology that uses the formation of nanoparticles by combining metal and organic material derived from micro-organisms [63]. During the synthesis of such nanoparticles, phytochemicals or microbial enzymes with antioxidant properties are used. The hybrid nanoparticles prepared in this way exhibit unique chemical and physical properties compared to the starting components. The small size, large surface area, suitable structure and ability to oxidise biomolecules in the environment make nanoparticles exhibit antimicrobial activity [64].
Many scientific reports confirm the efficacy of nanoparticles in reducing fungal- and soil-borne plant diseases [65]. The interaction of metal nanoparticles or hybrid nanoparticles with virus particles, including TMV, is still poorly understood and described. There are few papers on this topic. The biological activity of silver nanoparticles and P. fluorescens bioactive compounds in reducing TMV in N. glutinosa was determined by Ahsan [42]. The author conducted a biological synthesis of AgNPs nanoparticles in the presence of AgNO3 and extracted broth from a P. fluorescens strain. He applied the obtained nanoparticles to young plants 24 h before TMV infection or incubated in vitro for 10 min with TMV inoculum, and the suspension thus prepared was applied to the plants in the greenhouse. According to the author, the AgNPs nanoparticles manifested clear antiviral activity by inactivating the virus through modification of the capsid proteins. At the same time, the efficacy of AgNPs composites, when applied with the virus inoculum, was found to be significantly higher (92.7%) than when applied 24 h prior to TMV infection (41.4%). Nevertheless, the results obtained must be validated empirically in field experiments.
3. The Use of Fungi in the Bioprotection of Solanaceaous Crops against Tobacco Mosaic Virus
3.1. Filamentous Fungi
Many species of saprophytic fungi are an excellent, yet largely unutilized, source of substances with diverse activities. In addition to macromolecular compounds such as polysaccharides, glycoproteins, glycopeptides or proteins, the main compounds with antiviral activity are also low-molecular compounds, including phenols, quinones, cerebrosides and catechols [66].
3.1.1. Fusarium oxysporum and Alternaria spp.
A rich source of antiviral compounds are fungi classified as plant pathogens, including the species Fusarium oxysporum (Schlecht. Emend. Snyder and Hansen). This polyphagous species is adapted to live in a wide range of environmental conditions. Pathogenic forms of this species cause large economic losses in the cultivation of many crops such as maize, wheat, banana, cotton and many others. The mycelium of F. oxysporum (Figure 2B) is a source of many compounds from the glycosphingolipid group, such as cerebrosides and glucosylceramides, among others, which find applications in plant bioprotection due to their chemical properties and spatial structure.
Figure 2.
Colony morphology of Trichoderma spp. (A) and Fusarium oxysporum (B) after 28 days of growth on potato dextrose agar (PDA) at 25 °C in darkness (bar = 10 mm). Source: author’s documentation.
Studies by Umemura et al. [67] and Naveen et al. [68] have shown that cerebrosides derived from Fusarium are elicitors for plant resistance to fungal pathogens. Bernardino et al. [43] were the first in the world to study the activity of three glucosylceramides (GlCer) with m/z 760, 776 and 790 in protecting N. tabacum cv. Xanthi against TMV. The biologically active compounds were obtained by extraction and subsequent purification of lipid fractions extracted from F. oxysporum cell walls. The application of GlCer 24 h prior to TMV inoculation resulted in a marked reduction of virus titer and necrotic lesions. The observed reduction in symptoms after 72 h, in comparison to the control (treated only with phosphate buffer, which served as a solvent for GlCer), ranged from 41.8% to 75%, depending on the position of the leaves on the stem. Glucosylceramides were also effective in reducing lesions (from 27.8 to 36.0%) in tobacco plants already infected with the virus and, in addition, were effective inducers of reactive oxygen radicals (ROS). Analysis of the transcriptome of tobacco, whose leaves were treated with glucosylceramides and then infected with TMV, showed that the elicitation treatment resulted in the increased expression of a number of genes considered to be major markers of systemic acquired resistance (SAR), including genes encoding pathogenesis-related proteins (PR1), proteins with β-1,3-glucanase activity (PR2), chitinases (PR3), osmotin (PR5), phenylalanine ammonia lyase (PAL), lipoxygenase (LOX) and peroxidase (POX) (Figure 3).

Figure 3.
Defence processes against tobacco mosaic virus (TMV) using fungi. Multifaceted effects of glucosylceramides and cerebrosides extracted from Fusarium oxysporum cell wall and applied foliarly 24 h prior to inoculation with TMV. ROS—reactive oxygen species, which among other things, play a role in the control and regulation of biotic stress reaction; PR1, PR2, PR3, PR5—pathogenesis-related proteins; PAL—phenylalanine ammonia lyase; LOX—lipoxygenase; POX—peroxidase TMV—tobacco mosaic virus. Source: authors’ elaboration.
For example, application of GlCer 24 h before mechanical inoculation of N. tabacum cv. Xanthi resulted, a 147.7-fold increase in PR1 expression compared to that recorded in control plants inoculated with TMV alone. Equally significant expression relative to the control was recorded for PR2 and PR3 genes, 104.5 and 454.8 times higher, respectively [43]. In contrast, electron microscopy analysis showed that in vitro incubation of F. oxysporum glucosylceramides with TMV did not adversely affect the morphology of the virus particles, but caused them to aggregate into larger clusters. However, the aggregation of virus particles did not result in a decrease in TMV virulence, which was confirmed by the results of observing lesions on plants.
Literature reports indicate that, in addition to F. oxysporum, the species Alternaria tenuissima (Kunze) Wiltshire) is also used in the bioprotection of tobacco against TMV. This cosmopolitan fungus is found in a variety of environmental conditions, on a variety of host plants. It frequently colonises blueberries, tomatoes, vines and potatoes. Using chromatographic, purification and ultrafiltration methods of in vitro cultures of A. tenuisima, a thermo-stable protein 1 (Hrip 1) was extracted, which, when applied to the leaves of N. tabacum cv. Samsun-NN activated a number of defence mechanisms in the form of leaf hypersensitivity reactions, accumulation of hydrogen peroxide (H2O2) and nitric oxide, compounds directly or indirectly involved in the plant defence response against infection, as well as enhancing the expression of PR-1, LOX and ERF1 genes involved in the induction of salicylic acid (SA) and jasmonic acid (JA) synthesis in plants. The increased levels of PR proteins, together with the production of H2O2 and the subsequent lignification of the cell wall, were identified as key factors contributing to SAR and increased resistance to TMV [44].
3.1.2. Trichoderma and Sepedonium spp.
Trichoderma spp. (Figure 2A) and Sepedonium spp. also have high antimicrobial activity. These fungi are found in various climatic zones, are saprophytes and inhabit the root zone of plants. Trichoderma spp. and Sepedonium spp. show strong antagonistic properties against a number of pathogenic fungi such as Fusarium spp., Rhizoctonia solani (J.G. Kühn), Sclerotinia sclerotiorum (Lib.) de Bary, Colletotrichum spp., Rhizopus spp. The mechanism of their antagonistic action involves the increased production of hydrolytic enzymes such as cellulases, xylanases, pectinases, glucanases, as well as the synthesis of a broad spectrum of antibiotic-like compounds that inhibit the growth and development of pathogenic fungi and bacteria [69,70].
A well-recognised group of peptide antibiotics produced by Trichoderma spp. and Sepedonium spp. are peptaibols [45]. These metabolites show strong antiviral activity. Research by Yun et al. [45] in the early 2000s showed that treatment of N. tabacum cv. Xanthi with active peptaboils, named peptaivirin A and B, reduced infection caused by TMV by 74 and 79%, respectively. Subsequent experiments confirmed the antiviral efficacy of peptavirins A and B extracted from Apiocrea sp. 14T, but did not clarify their mechanism of action [46]. Luo et al. [47] investigated the efficacy of trichokonins—peptaboils extracted from T. pseudokoningii SMF2 in the biological protection of N. tabacum cv. Samsun NN against TMV and demonstrated their multifaceted effects. Application of 1 mL of trichoconins at a low concentration 100 nM to plants at the 8–10 leaf stage, made 4 days before virus inoculation, resulted not only in a 54% reduction in the number of lesions on the leaves, but also in a 57% reduction in their diameter, compared to that recorded on control plants. In a further experiment, a markedly increased production of reactive oxygen species (O2− and H2O2) and phenolic compounds in leaves—components involved in the early plant defence response when exposed to the pathogen—was observed following treatment of tobacco with peptide antibiotics. Based on the results, it can be concluded that trichconins induced resistance to TMV in tobacco by priming an elicitor-like cellular defence response. The purified homogenate of T. pseudokoningii SMF2 additionally caused an increase in phenylalanine ammonia lyase (PAL) and peroxidase (POD) activities. PAL and POD activities increased until the 4th day after peptabolis application, and reached values of 8.4 times (PAL) and 5.2 times (POD), respectively, higher than those recorded in control plants. This effect was observed until the 5th day after application, after which a decrease in pathogenesis-related enzymes was noted, which may indicate the need for repeat treatment. In addition to increased enzymatic activity, trichoconins increased the expression of NtPR1a and NTPR3 genes involved in plant defence mechanisms [47].
Furthermore, Trichoderma spp. can positively influence plant growth, photosynthesis and gas exchange [70,71]. Such a phenomenon has been observed, among others, in the tomato cv. Carmen. Soil application of a rhizospheric strain of T. hamatum Th23 resulted in a statistically significant improvement in plant growth parameters compared to the positive control treated with water. Moreover, the application of the Th23 strain 48 h prior to TMV inoculation of the tomato clearly delayed the appearance of mosaic lesions on the leaves and resulted in a significant reduction in virus accumulation in plant tissues compared to the positive control (treated only with TMV). At the same time, a significant increases in stem length and fresh and dry weights were recorded—74.35, 91.06 and 42.16%, respectively—as well as an increase in total chlorophyll content. Similarly, the root system showed a notable increase in length and fresh and dry weights, with increases of 95.08%, 94.75% and 45.05%, respectively, following treatment of the tomato plant with Th23. The application of Th23 on tomato plants was also accompanied by a number of biochemical changes in the leaves, including a significant increase in the activities of the three antioxidant enzymes SOD (84.38%), CAT (67.65%) and PPO (polyphenoloxidase) (210%), compared to those recorded for the control (treated with TMV only) [48]. The results clearly indicate that Th23 application stimulates the early plant defence mechanism and that SOD and PPO play a key role in ROS detoxification. Moreover, qRT-PCR transcriptional analysis in Th23 + TMV plants revealed the colonisation of tomato roots by T. hamatum (Bonord.) Bainier resulted in an increase in phenylpropanoid pathway gene transcripts (CHS and HQT). HQT gene activity increased almost 4-fold in comparison to the water-treated control. The high activity of the HQT and CHS genes consequently led to an increased production of phenylpropanoids and their derivatives, flavonoids and polyphenols, which have important protective roles in plants and exhibit antiviral properties [72]. The data obtained indicate that Th23 may stimulate the host’s resistance system and/or trigger SAR, which could result in TMV suppression and/or replication inhibition. In turn, the enhanced synthesis of antioxidant enzymes, such as SOD and PPO, serves to limit tissue oxidation and pathogen invasion by enhancing the structural integrity of cell walls.
3.1.3. Other Filamentous Fungi
It was also found that malformin A1, a cyclic penta-peptide extracted from Aspergillus tubingensis, possesses an inhibitory effect against the infection and replication of TMV when it was applied to both leaf and leaf discs of N. glutinosa [54]. In addition, Tan et al. [55] proved that purified polysaccharide (cytosporones U) produced by Phomopsis sp. FJBR-11 showed inhibitory activity against TMV. In a series of greenhouse experiments, TMV was found to be susceptible to crude methanol extracts derived from Neosartorya fischeri and Penicillium oxalicum 0312F1 [53,73]. Studies utilising P. oxalicum 0312F1 extracts applied seven hours after TMV inoculation of N. tabacum leaves demonstrated that the contained metabolites, including 2-(4-hydroxybenzyl) quinazolin-4(3H)-one and methyl 4-hydroxyphenylacetate, applied at a dose of 200 µg mL−1, exhibited inhibitory activity against replication of TMV. The inhibitory effect of the aforementioned metabolites was 72.17 and 64.90%, respectively, and was significantly higher than that obtained with controls (45.19%) treated with ribavirin, a commercial antiviral drug [53].
3.2. Woody–Rotting Fungi
Among the saprophytic fungi that are utilised in the bioprotection of tobacco against TMV is Coriolus versicolor (L.) Lloyd, a wood-rotting fungus of the family Polyporaceae. Extensive biochemical research has demonstrated the presence of a number of compounds with antiviral activity in the fruiting bodies of the fungus. These include polysaccharides, including the polysaccharide peptide PSP, which is biodegradable, replenishable and safe [74]. The antiviral activity of PSP in reducing TMV on N. tabacum cv. K326 and N. glutinosa was investigated by Zhao et al. [49]. In a series of parallel experiments, the researchers demonstrated that the effectiveness of the polysaccharide depended on the method of application and the dose. The use of PSP at a dose of 500 µg mL−1 resulted in a significantly superior protective and curative effect compared to the use of doses of 100, 200 and 400 µg mL−1, as well as a commercial preparation containing 500 µg mL−1 of ninganmycin. Furthermore, it was demonstrated that prior incubation of the virus (TMV at 6 × 10−3 mg mL−1) with PSP resulted in significantly enhanced virus inactivation compared to that observed when TMV was incubated with ningamycin. Additionally, it was shown that the application of PSP 12 h prior to TMV inoculation resulted in a reduction in the number of lesions on the leaves. In another parallel experiment, it was observed that PSP induced a defence response in N. tabacum and N. glutinosa plants, including an increase in PAL and POD activity in leaves and the expression of PR1a and PR5 genes, which condition the production of pathogenesis-related proteins. Additionally, the antiviral activity was demonstrated by direct interaction with virus particles and their assembly into aggregates. Despite the proven high efficacy against TMV, a significant challenge to the use of polysaccharide peptides as a commercial disease control agent may be the low productivity of the active ingredient or the high cost of production.
3.3. Edible Mushrooms
Some edible mushroom species are capable of producing substances with antiviral activity. Studies conducted on Lentinula edodes (Berk.), Coprinus comatus (O.F. Müll.) Pers., Plearotus citrinopileatus (Singer) and Flammulina velutipes (Curtis) Singer have shown that the polysaccharides and polysaccharide peptides they contain are compounds involved in the induction of systemic resistance to TMV [73,75,76]. The fruiting bodies of L. edodes are a rich source of lentinan (β-1,3 glucan), a polysaccharide that exhibits a strong anti-TMV effect in addition to its antibacterial activity. As reported by Wang et al. [50], the biological activity of L. edodes polysaccharides (LTN) is most often manifested in the early phase of infection by hindering virus adsorption on the surface of recipient cells and inhibiting the reverse transcriptase of virus. Inoculation of young plants of N. tabacum cv. Samsun NN with lentinan at a dose of 7.5 µg mL−1 induced a range of defence responses including: a reduction in the disease index and a rapid release of H2O2 in leaves, at values 1.6 fold higher than those in control plants (treated with ninganmycin 500 µg mL−1). Moreover, the application of sulfated LTN (sLTN) resulted in an increase in the expression of pathogenesis-related genes including genes encoding stilbene synthase (STS), glucanase (GLU1), serine-protease inhibitor (PIN), polygalacturonase-inhibiting protein (PGIP), acidic chitinase class IV (CHIT4c), phenylalanine ammonia lyase (PAL) and 5-epi-aristolochene synthase (EAS). The increased gene activity lasted for a relatively brief period, ranging from 24 to 48 h post-sLTN application. Subsequently, transcript levels of these genes decreased slowly, which indicates a short-term effect of LTN. Extracted from L. edodes, lentinan has also demonstrated the capacity to inhibit TMV multiplication by reducing the transcription of the TMV–CP gene. Similarly, polysaccharides extracted from the fruiting bodies of Coprinus comatus, Plearotus citrinopileatus and Flammulina velutipes demonstrated potent antiviral activity, limiting the proliferation of TMV and reducing infection when applied prior to tobacco inoculation with TMV [73,75,76].
Substances with antiviral activity isolated from fungal fruiting bodies also include proteins. Extracts from the fruiting bodies of Agrocybe aegerita (DC.) Vizzini and Angelini at a concentration of 200 µg mL−1 effectively reduce TMV infection (84.3%) on N. glutinosa [51]. The Agrocybe aegerita lectin it contains has been shown to bind to virus particles, thereby inhibiting viral infection, replication and systemic spread. Additionally, proteins termed xb68Ab with a molecular weight of 23.7 kD, obtained by ion-exchange chromatography and the gel filtration of the dry fruiting bodies of Pleurotus eryngii (DC.) Quél, showed antiviral activity against TMV [52]. The inhibition rate against TMV on N. glutinosa was 99.43%. It is suggested that proteins extracted from the fruiting bodies of A. aegerita and P. eryngii have antioxidant properties and act on the initial processes of virus replication. Therefore, they may be considered as a potential source of substances against TMV. Nevertheless, confirmation of their effectiveness still requires the completion of numerous experiments conducted under field conditions.
4. The Use of Actinomycetes in the Bioprotection of Solanaceous Plants against TMV
Also among the group of micro-organisms that produce compounds effective at biological crop protection are actinomycetes. These are aerobic Gram-positive bacteria that resemble filamentous fungi due to their ability to produce pseudomycetes [77]. They are commonly found in soil, compost, water and bottom sediments, where they are involved in the decomposition of plant and animal residues. They produce cellulolytic enzymes (cellulases, chitinases and xylanases), a number of antibiotics and a variety of compounds with antibacterial, antifungal and antiviral activity.
Among the numerous actinomycetes, species of the genus Streptomyces play a particularly significant role in the production of antiviral molecules. The results of a recent study indicate that S. cellulosae isolate Actino 48 reduced TMV proliferation in tomato and delayed the onset of mosaic symptoms by three days compared to plants inoculated with TMV alone [56]. The foliar application of Actino 48 cell suspension (2 × 107 CFU mL−1) carried out 48 h before TMV infection clearly stimulated the systemic resistance mechanism of tomato, as manifested by a significant increase in the activity of antioxidant enzymes, including peroxidase and chitinase. The total phenolic content in plants treated with Actino 48 was found to be 13.6 mg g−1, which was comparable to that of the control (14.6 mg g−1). In contrast, the inoculated plants exhibited a significantly lower content, at 2.8 mg g−1. It was additionally demonstrated that Actino 48 induces the activation of transcription factors, which in turn results in increased expression levels of PAL, PR-1 and CHS (1.6-, 2.1- and 1.4-fold changes, respectively, higher than the control). According to the authors, the Actino 48 isolate does not induce phytotoxic effects on plants and can be used as a biological agent in the reduction of TMV in tomato cultivation. However, they emphasise that further examinations are needed for analyzing potential field and commercial applications.
Scientific reports published by the Chengdu Institute of Biology in 1995 demonstrated that the radicle Streptomyces noursei (Brown) var. xichangensis produces a cytosine nucleotide peptide, ningnanmycin (NNM), with potent antimicrobial properties. Efficacy studies of NNM under field conditions have shown that it protects a range of crops against fungal and bacterial diseases [78]. In addition, it can inhibit the proliferation of plant pathogenic viruses, including TMV [57]. The S. noursei var. xichangensis strain and the ningamycin isolated from it were used in studies on the induction of systemic resistance to TMV in tobacco. Han et al. [57] conducted a comprehensive analysis of a range of plant biochemical and genetic traits. They assessed the chlorophyll and carotenoid content of the leaves of nine tobacco research groups, comparing healthy (control) plants, TMV-infected plants, NNM-treated plants and NNM-treated plants 1, 5 and 10 days before TMV inoculation, or 1, 5 and 10 days after TMV inoculation. The authors observed that, in the NNM-treated group prior to virus treatment, the chlorophyll and, especially, carotenoid contents were similar to those recorded in control plants, while in the group treated only with NNM, these values were much higher. The high carotenoid content protected the photosynthetic apparatus of the plants from the negative effects of TMV. Furthermore, the researchers observed that ningnanmycin disrupts the polymerisation of the viral CP protein by inhibiting the spread of TMV in the plant. Furthermore, the researchers showed that the treatment of plants with ningnanmycin at 200 µg mL−1 resulted in a greater accumulation of PR proteins—similar to ribonucleases and characterised by ribonuclease activity—than that observed with SA application (5 mM). These proteins may play a crucial role in the induction of SAR resistance against TMV. Additionally, NNM application 5 days after TMV inoculation resulted in an increase in the activity of NPR1 and JAZ3 genes, which encode proteins that activate the JA signalling pathway, via which ISR resistance is determined. According to the authors, the extraction of ningnanmycin from S. noursei var. xichangensis induced systemic resistance to TMV in tobacco through the activation of multiple plant-defence signalling pathways.
An important role in antiviral activity is also played by Streptomyces sp. ZX01, which was isolated from the rhizosphere of trees growing near Kanas Lake in China [79]. Its mycelium is an excellent source of secondary metabolites, which show strong antiviral activity. The acetyl-ethyl and N-butanol extracts from cultures of strain ZX01 have been shown to contain, among others, the thermosensitive glycoprotein GP-1 which, when applied to N. glutinosa, showed anti-TMV activity. Filtrates of Streptomyces naganishii (Yamaguchi and Saburi), S. michiganensis (Corbaz) and S. erythraeus (Waksman) have been identified as equally valuable sources of tobacco mosaic-restricting substances on N. glutinosa [58]. Studies conducted with them indicate that they can be used as natural agents in the protection against TMV.
5. Cross-Protection in Virus Control
A specific form of biocontrol of tobamoviruses, including TMV, is cross-protection, which can be defined as an antagonistic interaction between viruses. The phenomenon of cross-protection is defined as the inhibition of vital activities of a second, usually related, virus by an isolate inhabiting the tissues of a host plant [80]. This was first observed by McKinney, who demonstrated that infection with a ‘light-green’ mosaic virus provides protection against a ‘yellow’ mosaic virus in tobacco [81]. The core of cross-protection is the phenomenon of RNA silencing of the viral ‘intruder’, which is also known as post-transcriptional gene silencing (PTGS) [25]. This method has been, and continues to be, exploited in practice, where the infection of plants with a mild or attenuated strain protects them from infection from a more virulent strain. Holmes [82] developed a mild isolate of TMV by subjecting a virulent isolate of TMV to heat treatment, and reported that the symptoms caused by infection from the virulent isolate were suppressed in plants infected with the mild one. Slavokhotova et al. [83] demonstrated that the use of an attenuated VIROG-43 M strain resulted in plant protection against a tobamovirus-derived pathogenic strain of cucumber green mottle mosaic virus (CGMMV). Cross-protection has been demonstrated in numerous tobamoviruses, including tomato mosaic virus-L (ToMV-L), tomato brown rugose fruit virus (ToBRFV) [84] and tobacco mild green mosaic virus (TMGMV) [85]. This is a very effective method of the biocontrol of viruses, nevertheless, the practical applicability of this approach gives rise to a number of questions. One of the most challenging aspects of this process is determining how to source attenuated strains. It is not always easy to find strains that are non-pathogenic to other species, save for the ecosystem and the consumer [84]. Furthermore, the strain must be easy to produce and genetically stable. The presence of a mild strain of the virus may result in a reduction in yield when infecting plants. Infected plants serve as a reservoir for the virus, which can mutate into an aggressive strain. Additionally, mixed infections with another non-related virus can result in the development of a dangerous disease. Moreover, the inoculation of plants with the virus in field conditions represents a significant labour input, particularly in the case of annual plants.
6. A Summary and Perspectives on Using Micro-Organisms for Bioprotection against TMV
With increasing public awareness of the risks associated with the use of pesticides in agriculture, more sustainable and environmentally friendly plant-protection techniques are being explored. There is growing interest in the use of bioprotectants (living biocontrol agents and non-living, nature-based substances) that can not only induce plant resistance but also prevent many viral infections, including TMV. Studies at several research centres have shown that bacteria of the genera Bacillus, Pseudomonas and Streptomyces predominate among the micro-organisms used to reduce TMV in Solanaceae plants [33]. Suspensions of the abovementioned micro-organisms, as well as filtrates derived from their cultures applied to soil or foliar, stimulate the activation of acquired resistance to SAR and induce plant-defence reactions in the form of increased activity of antioxidant enzymes (SOD, POD, CAT). They have also been reported to have a direct effect on the pathogen by blocking the activity of viral enzyme proteins, preventing viral entry into cells or slowing viral replication [40,57,86]. According to Han et al. [57], Streptomyces noursei var. xichangensis produces antibiotics that induce systemic plant resistance to TMV. A well-known and widely used commercial antibiotic in agriculture is ningnanmycin—a cytosine nucleotide peptide that is effective in reducing the spread of TMV and inducing SAR resistance in tobacco or tomato.
Another large group of bioprotectants are based on saprophytic fungi belonging to Trichoderma spp. and Sepedonium spp. These micro-organisms have been shown to produce peptide antibiotics (peptaboils) with multifaceted anti-TMV activity [45]. Peptaboils reduce the extent of mosaic lesions and necroses on leaves, induce an increase in the activity of PAL and POD enzymes involved in the induction of defence mechanisms and induce an increase in the expression of genes involved in the production of antioxidant enzymes [47,72]. Some strains of Trichoderma spp. have also been shown to promote plant growth, increase nutrient uptake and improve fertiliser-use efficiency, in addition to stimulating defence mechanisms [71]. On the other hand, edible mushrooms that are a source of lentinan have a direct effect on TMV by reducing TMV—CP gene translation and viral protein production [50].
The implementation of the EU directive on the sustainable use of pesticides and integrated pest management is contributing to an increase in efforts related to the use of biological agents in crop protection. However, the range of available bioactive compounds, micro-organisms dedicated to the reduction of tobacco mosaic virus in crops, is limited [59]. In addition, the majority of agents are classified as preventive agents, applied prior to virus inoculation. As shown in this paper, most of them have a non-permanent effect on TMV. Only a small proportion of them have direct antiviral activity and can be used to control TMV under greenhouse conditions. It is advisable to search for new compounds with higher activity and efficacy against TMV, and to expand the range of available protective formulations. In addition, the products on the market need to be applied in large quantities, which is often economically unjustified and unacceptable for agricultural practice [87,88].
It should be noted that studies to date have mainly focused on evaluating the efficacy of biological agents in preventing TMV infection and reducing disease symptoms. Much more attention should be paid to understanding the mechanisms of action of bioactive compounds, especially those with a molecular basis. It will also be of interest to determine the efficacy of bioprotectants under field conditions, i.e., in an environment characterised by varying temperatures, soil and air humidity, sunlight and a high complexity of different types of competitive interactions between micro-organisms. This is because most studies to date have been conducted in laboratory or under glass, where conditions are strictly or partially controlled [89].
Notwithstanding the strong support for the development of biological methods for plant protection, the extent of their utilisation remains inadequate and fails to align with their full potential in agricultural applications. The primary factor contributing to the unsatisfactory utilisation of biological agents in practice is the prolonged and costly registration process. To illustrate this, the evaluation process in the EU requires a period of more than 70 months, whereas in the United States it necessitates only 23 months. The financial outlay required to obtain approval for the registration of a novel biopreparation in the United States is estimated at $2 million, while the expected annual net profit from optimal surface application is approximately $200,000 [90]. A further limitation to the utilisation of bioprotectants is their inherent instability and susceptibility to deterioration during storage, particularly at elevated temperatures. Consequently, it is not always feasible to transfer their efficacy from the laboratory to the field. For example, numerous strains of Pseudomonas spp. and Bacillus spp. bacteria have shown efficacy in trials under controlled conditions [91]. However, their effectiveness in field conditions has been limited. It is therefore important to identify BCA that demonstrate stable efficacy over a range of environmental conditions, including soil texture, moisture levels, temperature extremes and competition from other micro-organisms [92,93].
Rodrigues et al. [94] maintain that bioprotectants, in comparison to chemical ones, are safer for both the environment and the humans who apply them. However, the use of bioprotectants to protect crops, especially those intended for human consumption, will require a number of studies, both toxicological and epidemiological. Given the high genetic variability of bacteria and fungi, as well as the possibility of interaction with other organisms co-existing in the ecological niche, it also seems appropriate to carry out studies to determine the long-term impact of introduced beneficial organisms on the host and the ecosystem. It would also be worthwhile to gain a better understanding of the biochemical structure of bioactive compounds in order to intensify the methods of biosynthesis of antiviral compounds and the involvement of industry in their production. The industrialisation of new bioprotectants should focus on formulations with the highest anti-TMV activity and easy applicability.
Funding
This study was financed within the framework of task 1.6.1 from a targeted grant for the implementation of the tasks of the Polish Ministry of Agriculture and Rural Development for 2024.
Acknowledgments
Thanks are due to Anna Depta, and Diana Czarnecka, for providing photographs of N. tabacum cv. Ambalema and the colony of Fusarium oxysporum and Trichoderma spp.
Conflicts of Interest
The author declares no conflicts of interest.
References
- Scholthof, K.B.G.; Washington, L.J.; De Mell, A.; Mendoza, M.R.; Cody, W.B. Practicing virology: Making and knowing a mid-twentieth century experiment with Tobacco mosaic virus. Hist. Philos. Life Sci. 2022, 44, 3. [Google Scholar] [CrossRef] [PubMed]
- Rifkind, D.; Freeman, G.L. Tobacco mosaic virus. In The Nobel Prize Winning Discoveries in Infectious Diseases; Rifkind, D., Freeman, G.L., Eds.; Academic Press: Cambridge, MA, USA, 2005; pp. 81–84. [Google Scholar] [CrossRef]
- Da Silva, R.M.; de Soutol, E.R.; Pedrosol, J.C.; Arakava, R.; Almeida, A.M.R.; Barbozal, A.A.L.; Vidal, J.B. Detection and identification of TMV infecting tomato under protected cultivation in Parana State. Braz. Arch. Biol. Technol. 2008, 51, 903–909. [Google Scholar] [CrossRef]
- Chen, J.; Luo, X.; Chen, Y.; Wang, Y.; Peng, J.; Xing, Z. Recent Research Progress: Discovery of Anti-Plant Virus Agents Based on Natural Scaffold. Front. Chem. 2022, 10, 926202. [Google Scholar] [CrossRef] [PubMed]
- Yin, H.; Zhao, X.; Du, Y. Oligochitosan: A plant diseases vaccine—A review. Carbohydr. Polym. 2010, 82, 1–8. [Google Scholar] [CrossRef]
- Korbecka-Glinka, G.; Przybyś, M.; Feledyn-Szewczyk, B. A survey of five plant viruses in weeds and tobacco in Poland. Agronomy 2021, 11, 1667. [Google Scholar] [CrossRef]
- Alexandre, M.A.V.; Soares, R.M.; Rivas, E.B.; Duarte, L.M.L.; Chagas, C.M.; Saunal, H.; van Regenmortel, M.H.V.; Richtzehain, L.J. Characterization of a strain of Tobacco mosaic virus from Petunia. J. Phytopathol. 2000, 148, 601–607. [Google Scholar] [CrossRef]
- Kumar, S.; Udaya, S.A.; Nayaka, S.C.; Lund, O.S.; Prakash, H.S. Detection of Tobacco mosaic virus and Tomato mosaic virus in pepper and tomato by multiplex RT-PCR. Lett. Appl. Microbiol. 2011, 53, 359–363. [Google Scholar] [CrossRef] [PubMed]
- Pazarlar, S.; Gümüs, M.; Öztekin, G.B. The Effects of Tobacco mosaic virus Infection on Growth and Physiological Parameters in Some Pepper Varieties (Capsicum annuum L.). Not. Bot. Horti Agrobot. Cluj-Napoca 2013, 41, 427–433. [Google Scholar] [CrossRef]
- Pernezny, K.; Roberts, P.; Murphy, J.; Goldberg, N. Compendium of Pepper Diseases; American Phytopathological Society: St. Paul, MN, USA, 2003. [Google Scholar]
- Chitra, T.R.; Prakash, H.S.; Albrechtsen, S.E.; Shetty, H.S.; Mathur, S.B. Indexing of leaf and seed samples of tomato and bell pepper for tobamoviruses. Indian Phytopathol. 2002, 55, 84–86. [Google Scholar]
- Rao, G.P.; Reddy, M.G. Chapter 38—Overview of yield losses due to plant viruses. In Applied Plant Virology; Awasthi, L.P., Ed.; Academic Press: Cambridge, MA, USA, 2020; pp. 531–562. [Google Scholar] [CrossRef]
- Di Candilo, M.; Faccioli, G.; Grassi, G.; Faeti, V. Effect of tomato mosaic virus (ToMV) on yield of machine-harvested processing tomatoes. Phytopathol. Mediterr. 1992, 31, 32–36. [Google Scholar]
- Salazar, L.F. Potato Viruses and Their Control; International Potato Center (CIP): Lima, Peru, 1996; p. 214. [Google Scholar]
- Jung, H.W.; Yun, W.S.; Hahm, Y.I.; Kim, K.H. Characterization of Tobacco mosaic virus Isolated from Potato Showing Yellow Leaf Mosaic and Stunting Symptoms in Korea. Plant Dis. 2002, 86, 112–117. [Google Scholar] [CrossRef] [PubMed][Green Version]
- Scholthof, K.-B.G. Tobacco Mosaic Virus: The Beginning of Plant Pathology. APSnet Features 2008. Available online: https://www.apsnet.org/edcenter/apsnetfeatures/Pages/TMV.aspx (accessed on 24 June 2021). [CrossRef]
- Liu, Y.; Wang, Z.; Qian, Y.; Mu, J.; Shen, L.; Wang, F.; Yang, J. Rapid detection of tobacco mosaic virus using the reverse transcription loop-mediated isothermal amplification method. Arch. Virol. 2010, 155, 1681–1685. [Google Scholar] [CrossRef] [PubMed]
- Melton, T.A.; Gutierrez, W.A.; Broadwell, A.; Wilson, J. Plant Pathology Department Extension-Research Flue-Cured Tobacco Disease Report; North Carolina Cooperative Extension Service: Raleigh, NC, USA, 2000. [Google Scholar]
- Karavina, C.; Changaya, A. Chapter 25—Tobacco. In Viral Diseases of Field and Horticultural Crops; Awasthi, L.P., Ed.; Academic Press: Cambridge, MA, USA, 2024; pp. 207–212. [Google Scholar] [CrossRef]
- Lewandowski, D.J.; Hayes, A.J.; Adkins, S. Surprising results from a search for effective disinfectants for Tobacco mosaic virus contaminated tools. Plant Dis. 2010, 94, 542–550. [Google Scholar] [CrossRef] [PubMed]
- Jeżewska, M.; Trzmiel, K. Tobacco mosaic virus (tmv) in winter barley—Transmission with seeds. Phytopathol. Pol. 2005, 38, 103–106. [Google Scholar]
- Cannon, J.R.; Greenamyre, J.T. The role of environmental exposures in neurodegeneration and neurodegenerative diseases. Toxicol. Sci. 2011, 124, 225–250. [Google Scholar] [CrossRef] [PubMed]
- International Biocontrol Manufacturers Association IBMA White Paper: New EU Regulatory Framework for Bioprotection Agents. 2018. Available online: https://www.ibma-global.org/upload/attach-document/ibma-white-paper-web-final-a5-spreads (accessed on 1 September 2018).
- Galli, M.; Feldmann, F.; Vogler, U.K.; Kogel, K.-H. Can biocontrol be the game-changer in integrated pest management? A review of definitions, methods and strategies. J. Plant Dis. Prot. 2024, 131, 265–291. [Google Scholar] [CrossRef]
- Hulot, J.F.; Hiller, N. Exploring the Benefits of Biocontrol for Sustainable Agriculture—A Literature Review of Biocontrol in Light of the European Green Deal; Institute for European Environmental Policy: London, UK, 2021; Available online: https://ieep.eu/publications/exploring-the-benefits-of-biocontrol-for-sustainable-agriculture (accessed on 24 June 2021).
- Baker, B.P.; Green, T.; Loker, A.J. Biological control and integrated pest management in organic and conventional systems. Biol. Control 2020, 140, 104095. [Google Scholar] [CrossRef]
- Stenberg, J.A.; Sundh, I.; Becher, P.G.; Björkman, C.; Dubey, M.; Egan, P.A.; Friberg, H.; Gil, J.F.; Jensen, D.F.; Jonsson, M.; et al. When is it biological control? A framework of definitions, mechanisms, and classifications. J. Pest Sci. 2021, 94, 665–676. [Google Scholar] [CrossRef]
- Zhang, C.S.; Kong, F.Y.; Liu, S.K.; Wang, X.F. Anti-TMV activity of Bacillus subtilis strain Tb55. Acta Tabacaria Sin. 2009, 15, 48–51. [Google Scholar]
- Odoh, C.K.; Eze, C.N.; Akpi, U.K.; Unah, V.U. Plant growth promoting rhizobacteria (PGPR): A novel agent for sustainable food production. Am. J. Agric. Biol. Sci. 2019, 14, 35–54. [Google Scholar] [CrossRef]
- Sobiczewski, P. Bakterie jako czynniki biologicznej ochrony roślin przed chorobami. Postępy Nauk. Rol. 1994, 6, 19–33. [Google Scholar]
- Pospieszny, H. Systemic Acquired Resistance (SAR) in integrated plant protection. Prog. Plant Prot. 2016, 56, 436–442. [Google Scholar] [CrossRef][Green Version]
- Bajguz, A.; Czerpak, R. Rola kwasu salicylowego w odpowiedziach obronnych na działanie patogenów. Kosmos 2001, 50, 49–59. [Google Scholar]
- Veselova, S.V.; Sorokan, A.V.; Burkhanova, G.F.; Rumyantsev, S.D.; Cherepanova, E.; Alekseev, V.Y.; Sarvarova, E.R.; Kasimova, A.R.; Maksimov, I.V. By Modulating the Hormonal Balance and Ribonuclease Activity of Tomato Plants Bacillus subtilis Induces Defense Response against Potato Virus X and Potato Virus Y. Biomolecules 2022, 12, 288. [Google Scholar] [CrossRef] [PubMed]
- De Meyer, G.; Audenaert, K.; Höfte, M. Pseudomonas aeruginosa 7NSK2-induced systemic resistance in tobacco depends on in planta Salicylic Acid accumulation but is not associated with PR1a Expression. Eur. J. Plant Pathol. 1999, 105, 513–517. [Google Scholar] [CrossRef]
- Gupta, A.K.; Verma, J.; Srivastava, A.; Srivastava, S.; Prasad, V. A comparison of induced antiviral resistance by the phytoprotein CAP-34 and isolate P1f of the rhizobacterium Pseudomonas putida. 3 Biotech 2021, 11, 509. [Google Scholar] [CrossRef]
- Zhou, W.-W.; Zhang, L.-X.; Zhang, B.; Wang, F.; Liang, Z.-H.; Niu, T.-G. Isolation and characterization of ZH14 with antiviral activity against Tobacco mosaic virus. Can. J. Microbiol. 2008, 54, 6. [Google Scholar] [CrossRef]
- Rajaofera, M.J.N.; Wang, Y.; Jatoi, Z.A.; Jin, P.; Cui, H.; Lin, C.; Miao, W. Bacillus atrophaeus HAB-5 secretion metabolites preventing occurrence of systemic diseases in tobacco plant. Eur. J. Plant Pathol. 2020, 156, 159–172. [Google Scholar] [CrossRef]
- Damayanti, T.A.; Pardede, H.; Mubarik, N.R. Utilization of Root-Colonizing Bacteria to Protect Hot-Pepper against Tobacco Mosaic Tobamovirus. HAYATI J. Biosci. 2007, 14, 105–109. [Google Scholar] [CrossRef]
- Aeini, M.; Ghodoum Parizipour, M.H.; Eftekhari, S.A.; Pooladi, P. Management of Tobacco mosaic virus by some plant probiotic bacteria in tomato plant. Biol. Control Pests Plant Dis. 2019, 7, 117–127. [Google Scholar] [CrossRef]
- Aeini, M.; Ghodoum Parizipour, M.H.; Eftekhari, S.A.; Pooladi, P. Application of plant growth-promoting rhizobacteria to protect bell pepper against Tobacco mosaic virus. J. Crop Prot. 2021, 10, 711–722. [Google Scholar]
- Liu, H.; Jiang, J.; An, M.; Li, B.; Xie, Y.; Xu, C.; Jiang, L.; Yan, F.; Wang, Z.; Wu, Y. Bacillus velezensis SYL-3 suppresses Alternaria alternata and tobacco mosaic virus infecting Nicotiana tabacum by regulating the phyllosphere microbial community. Front. Microbiol. 2022, 13, 840318. [Google Scholar] [CrossRef]
- Ahsan, T. Biofabrication of silver nanoparticles from Pseudomonas fluorescens to control tobacco mosaic virus. Egypt. J. Biol. Pest Control 2020, 30, 66. [Google Scholar] [CrossRef]
- Bernardino, M.C.; Couto, M.L.C.O.; Vaslin, M.F.S.; Barreto-Bergter, E. Antiviral activity of glucosylceramides isolated from Fusarium oxysporum against Tobacco mosaic virus infection. PLoS ONE 2020, 15, e0242887. [Google Scholar] [CrossRef]
- Kulye, M.; Liu, H.U.; Zhang, Y.; Zeng, H.X.; Yang, X.; Qiu, D. Hrip1, a novel protein elicitor from necrotrophic fungus, Alternaria tenuissima, elicits cell death, expression of defence-related genes and systemic acquired resistance in tobacco. Plant Cell Environ. 2012, 35, 2104–2120. [Google Scholar] [CrossRef]
- Yun, B.-S.; Young-Ho, K.; Ick-Dong, Y.; Kim, Y.-S.; Lee, S.-J.; Yeo, K.-S.; Yeo, W. ChemInform Absract: Peptavirins A and B, two new antiviral peptaibols against TMV infection. Tetrahedron Lett. 2000, 41, 1429–1431. [Google Scholar] [CrossRef]
- Yeo, W.H.; Yun, B.S.; Kim, Y.S.; Lee, S.J.; Yoo, I.D.; Kim, K.S.; Park, E.K.; Lee, J.C.; Kim, Y.H. Antiviral, Antimicrobial, and Cytotoxic Properties of Peptavirins A and B Produced by Apiocrea sp. 14T. Plant Pathol. J. 2002, 18, 18–22. [Google Scholar] [CrossRef]
- Luo, Y.; Zhang, D.D.; Dong, X.W.; Zhao, P.B.; Chen, L.L.; Song, X.Y.; Wang, X.J.; Chen, X.L.; Shi, M.; Zhang, Y.Z. Antimicrobial peptaibols induce defense responses and systemic resistance in tobacco against tobacco mosaic virus. FEMS Microbiol. Lett. 2010, 313, 120–126. [Google Scholar] [CrossRef]
- Abdelkhalek, A.; Al-Askar, A.A.; Arishi, A.A.; Behiry, S.I. Trichoderma hamatum Strain Th23 Promotes Tomato Growth and Induces Systemic Resistance against Tobacco Mosaic Virus. J. Fungi 2022, 8, 228. [Google Scholar] [CrossRef]
- Zhao, L.; Hao, X.; Wu, Y. Inhibitory effect of polysaccharide peptide (PSP) against Tobacco mosaic virus (TMV). Int. J. Biol. Macromol. 2015, 75, 474–478. [Google Scholar] [CrossRef] [PubMed]
- Wang, J.; Wang, H.-Y.; Xia, X.-M.; Li, P.-P.; Wang, K.-Y. Inhibitory effect of sulfated lentinan and lentinan against tobacco mosaic virus (TMV) in tobacco seedlings. Int. J. Biol. Macromol. 2013, 61, 264–269. [Google Scholar] [CrossRef] [PubMed]
- Sun, H.; Zhao, C.G.; Tong, X.; Qi, Y.P. A Lectin with Mycelia Differentiation and Antiphytovirus Activities from the Edible Mushroom Agrocybe aegerita. J. Biochem. Mol. Biol. 2003, 36, 214–222. [Google Scholar] [CrossRef] [PubMed]
- Fu, M.J.; Lin, J.Q.; Wu, Z.J.; Lin, Q.Y.; Xie, L.H. Screening of proteins anti-tobacco mosaic virus in Pleurotus eryngii. Acta Microbiol. Sin. 2003, 43, 29–34. [Google Scholar]
- Shen, S.; Li, W.; Wang, J. A novel and other bioactive secondary metabolites from a marine fungus Penicillium oxalicum 0312F1. Nat. Prod. Res. 2013, 27, 2286–2291. [Google Scholar] [CrossRef] [PubMed]
- Tan, Q.W.; Gao, F.L.; Wang, F.R.; Chen, Q.J. Anti-TMV activity of malformin A1, a cyclic penta-peptide produced by an endophytic fungus Aspergillus tubingensis FJBJ11. Int. J. Mol. Sci. 2015, 16, 5750–5761. [Google Scholar] [CrossRef] [PubMed]
- Tan, Q.W.; Fang, P.H.; Ni, J.C.; Gao, F.L.; Chen, Q.J. Metabolites Produced by an Endophytic Phomopsis sp. and their anti-TMV activity. Molecules 2017, 22, 2073. [Google Scholar] [CrossRef] [PubMed]
- Abo-Zaid, G.A.; Matar, S.M.; Abdelkhalek, A. Induction of Plant Resistance against Tobacco Mosaic Virus Using the Biocontrol Agent Streptomyces cellulosae Isolate Actino 48. Agronomy 2020, 10, 1620. [Google Scholar] [CrossRef]
- Han, Y.; Luo, Y.; Qin, S.; Xi, L.; Wan, B.; Du, L. Induction of systemic resistance against tobacco mosaic virus by Ningnanmycin in tobacco. Pestic. Biochem. Physiol. 2014, 111, 14–18. [Google Scholar] [CrossRef]
- Mohamed, S.; Galal, A.M. Identification and antiviral activities of some halotolerant Streptomycetes isolated from Qaroonlake. Int. J. Agric. Biol. 2005, 7, 747–753. [Google Scholar]
- Chen, J.; Liu, H.; Xia, Z.; Zhao, X.; Wu, Y.; An, M. Purification and Structural Analysis of the Effective Anti-TMV Compound ε-Poly-l-lysine Produced by Streptomyces ahygroscopicus. Molecules 2019, 24, 1156. [Google Scholar] [CrossRef] [PubMed]
- Miljakovic, D.; Marinkovic, J.; Baleševic-Tubic, S. The significance of Bacillus spp. in disease suppression and growth promotion of field and vegetable crops. Microorganisms 2020, 8, 1037. [Google Scholar] [CrossRef]
- Ongena, M.; Jacques, P. Bacillus lipopeptides: Versatile weapons for plant disease biocontrol. Trends Microbiol. 2008, 16, 115–125. [Google Scholar] [CrossRef] [PubMed]
- Kucharska, K.; Wachowska, U. Mikrobiom liści roślin uprawnych. Post. Mikrobiol. 2014, 53, 352–359. [Google Scholar]
- Elmer, W.; White, J.C. The Future of Nanotechnology in Plant Pathology. Annu. Rev. Phytopathol. 2018, 56, 111–133. [Google Scholar] [CrossRef] [PubMed]
- Wang, L.; Hu, C.; Shao, L. The antimicrobial activity of nanoparticles: Present situation and prospects for the future. Int. J. Nanomed. 2017, 12, 1227–1249. [Google Scholar] [CrossRef] [PubMed]
- León-Buitimea, A.; Garza-Cervantes, J.A.; Gallegos-Alvarado, D.Y.; Osorio-Concepción, M.; Morones-Ramírez, J.R. Nanomaterial-Based Antifungal Therapies to Combat Fungal Diseases Aspergillosis, Coccidioidomycosis, Mucormycosis, and Candidiasis. Pathogens 2021, 10, 1303. [Google Scholar] [CrossRef] [PubMed]
- Lacerda, Í.C.D.S.; Polonio, J.C.; Golias, H.C. Endophytic Fungi as a Source of Antiviral Compounds—A Review. Chem. Biodivers. 2022, 19, e202100971. [Google Scholar] [CrossRef] [PubMed]
- Umemura, K.; Tanino, S.; Nagatsuka, T.; Koga, J.; Iwata, M.; Nagashima, K.; Amemiya, Y. Cerebroside elicitor confers resistance to fusarium disease in various plant species. Phytopathology 2004, 94, 813–818. [Google Scholar] [CrossRef]
- Naveen, J.; Hariprasad, P.; Nayaka, S.C.; Niranjana, S.R. Cerebroside mediated elicitation of defense response in chilli (Capsicum annuum L.) against Colletotrichum capsici infection. J. Plant Interact. 2013, 8, 65–73. [Google Scholar] [CrossRef]
- Howell, C.R. Mechanisms employed by Trichoderma species in the biological control of plant diseases: The history and evolution of current concepts. Plant Dis. 2003, 87, 4–10. [Google Scholar] [CrossRef] [PubMed]
- Lodi, R.S.; Peng, C.; Dong, X.; Deng, P.; Peng, L. Trichoderma hamatum and its benefits. J. Fungi 2023, 9, 994. [Google Scholar] [CrossRef] [PubMed]
- Harman, G.E.; Herrera-Estrella, A.H.; Horwitz, B.A.; Lorito, M. Trichoderma—From basic biology to biotechnology. Microbiology 2012, 158, 1–2. [Google Scholar] [CrossRef] [PubMed]
- Leiss, K.A.; Maltese, F.; Choi, Y.H.; Verpoorte, R.; Klinkhamer, P.G. Identification of Chlorogenic Acid as a Resistance Factor for Thrips in Chrysanthemum. Plant Physiol. 2009, 150, 1567–1575. [Google Scholar] [CrossRef] [PubMed]
- Shen, S.; Li, W.; Ouyang, M.; Wu, Z.; Lin, Q.; Xie, L. Identification of two marine fungi and evaluation of their antivirus and antitumor activities. Acta Microbiol. Sin. 2009, 49, 1240–1246. [Google Scholar]
- Zhang, Y.; Zhang, G.; Ling, J. Medicinal Fungi with Antiviral Effect. Molecules 2022, 27, 4457. [Google Scholar] [CrossRef] [PubMed]
- Fu, M.J.; Wu, Z.J.; Lin, Q.Y.; Xie, L.H. Purification of an antiviral protein in Plearotus citrinopileatus and its activities against tobacco mosaic virus and Hepatitis B virus. Virol. Sin. 2002, 17, 350–353. [Google Scholar]
- Wu, Y.; Xie, L.; Xie, L.; Lin, Q.; Lin, S. A Preliminary Study on Anti-TMV Activity of Polysaccharide from Coprinus comatus. Chin. Agric. Sci. Bull. 2007, 23, 338. [Google Scholar] [CrossRef]
- Solecka, J.; Ziemska, J.; Rajnisz, A.; Laskowska, A.; Guśpiel, A. Promieniowce—występowanie i wytwarzanie związków biologicznie czynnych. Post. Mikrobiol. 2013, 52, 83–91. [Google Scholar]
- Xiang, G.; Hu, H.; Chen, J.; Chen, W.; Wu, L. A new agricultural antibiotic: Ningnanmycin. Acta Microbiol. Sin. 1995, 5, 368–374. [Google Scholar]
- Zhang, G.; Han, L.; Zhang, G.; Zhang, X.; Feng, J. Purification and characterization of a novel glycoprotein from Streptomyces sp. ZX01. Int. J. Biol. Macromol. 2015, 78, 195–201. [Google Scholar] [CrossRef] [PubMed]
- Hernando, Y.; Arado, M.A. Cross-protection against pepino mosaic virus, more than a decade of efficient disease control. Ann. Appl. Biol. 2024, 184, 174–182. [Google Scholar] [CrossRef]
- McKinney, H.H. Mosaic diseases in the Canary Islands, West Africa and Gibraltar. J. Agric. Res. 1929, 39, 557–578. [Google Scholar]
- Holmes, F.O. A masked strain of tobacco-mosaic virus. Phytopathology 1934, 24, 845–873. [Google Scholar]
- Slavokhotova, A.A.; Istomina, E.A.; Andreeva, E.A.; Korostyleva, T.V.; Pukhalskij, V.A.; Shijan, A.N.; Odintsova, T.I. An Attenuated Strain of Cucumber Green Mottle Mosaic Virus as a Biological Control Agent against Pathogenic Viral Strains. Am. J. Plant Sci. 2016, 7, 724–773. [Google Scholar] [CrossRef]
- Salem, M.M.; Jewehan, A.; Aranda, M.A.; Fox, A. Tomato Brown Rugose Fruit Virus Pandemic. Annu. Rev. Phytopathol. 2023, 61, 137–164. [Google Scholar] [CrossRef] [PubMed]
- Tomitaka, Y.; Shimomoto, Y.; Ryang, B.-S.; Hayashi, K.; Oki, T.; Matsuyama, M.; Sekine, K.-T. Development and Application of Attenuated Plant Viruses as Biological Control Agents in Japan. Viruses 2024, 16, 517. [Google Scholar] [CrossRef] [PubMed]
- Manjunatha, L.; Rajashekara, H.; Uppala, L.S.; Ambika, D.S.; Patil, B.; Shankarappa, K.S.; Nath, V.S.; Kavitha, T.R.; Mishra, A.K. Mechanisms of Microbial Plant Protection and Control of Plant Viruses. Plants 2022, 11, 3449. [Google Scholar] [CrossRef] [PubMed]
- Seiber, J.N. Sustainability and Agricultural and Food Chemistry. Agric. Food Chem. 2011, 59, 1–21. [Google Scholar] [CrossRef]
- Banat, I.M.; Franzetti, A.; Gandolfi, I.; Bestetti, G.; Martinotti, M.G.; Fracchia, L.; Smyth, T.J.; Marchant, R. Microbial biosurfactants production, applications and future potential. Appl. Microbiol. Biotechnol. 2010, 87, 427–444. [Google Scholar] [CrossRef]
- Pellegrini, M.; Pagnani, G.; Bernardi, M.; Mattedi, A.; Spera, D.M.; Gallo, M.D. Cell-Free Supernatants of Plant Growth-Promoting Bacteria: A Review of Their Use as Biostimulant and Microbial Biocontrol Agents in Sustainable Agriculture. Sustainability 2020, 12, 9917. [Google Scholar] [CrossRef]
- Jaronski, S. The challenges of commercializing microbial pest control agents in the U.S. In Proceedings of the XXIII International Congress of Entomology, Durban, South Africa, 6–12 July 2008. Abstract number 3534. [Google Scholar]
- Mark, G.L.; Morrissey, J.P.; Higgins, P.; O’Gara, F. Molecular-Based Strategies to Exploit Pseudomonas Biocontrol Strains for Environmental Biotechnology Applications. FEMS Microbiol. Ecol. 2006, 56, 167–177. [Google Scholar] [CrossRef] [PubMed]
- Zubair, M.; Hanif, A.; Farzand, A.; Sheikh, T.M.M.; Khan, A.R.; Suleman, M.; Ayaz, M.; Gao, X. Genetic Screening and Expression Analysis of Psychrophilic Bacillus spp. Reveal Their Potential to Alleviate Cold Stress and Modulate Phytohormones in Wheat. Microorganisms 2019, 7, 337. [Google Scholar] [CrossRef] [PubMed]
- Sehrawat, A.; Sindhu, S.S. Potential of Biocontrol Agents in Plant Disease Control for Improving Food Safety. Def. Life Sci. J. 2019, 4, 220–225. [Google Scholar] [CrossRef]
- Rodrigues, L.C.C.; Fortini, R.M.; Neves, C.R.M. Impacts of the use of biological pest control on the technical efficiency of the Brazilian agricultural sector. Int. J. Environ. Sci. Technol. 2023, 20, 1–16. [Google Scholar] [CrossRef]
Disclaimer/Publisher’s Note: The statements, opinions and data contained in all publications are solely those of the individual author(s) and contributor(s) and not of MDPI and/or the editor(s). MDPI and/or the editor(s) disclaim responsibility for any injury to people or property resulting from any ideas, methods, instructions or products referred to in the content. |
© 2024 by the author. Licensee MDPI, Basel, Switzerland. This article is an open access article distributed under the terms and conditions of the Creative Commons Attribution (CC BY) license (https://creativecommons.org/licenses/by/4.0/).